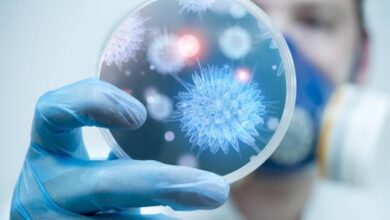

محتويات

ارتفاع اليوريك أسيد” Hyeruricemia”: هو فرط اليوريك أسيد في الدم؛ حيث إنّ معظمه يتم إخراجه عن طريق البول، ويتمّ إنتاجه من مركَب البيورين ( purines )؛ وهو مركب يحتوي على النيتروجين، ويمكن الحصول عليه داخل خلايا الجسم، أو من الأطعمة الغنيّة به، فزيادة نسبة هذا المركب، تؤدّي إلى تكوين كميات كبيرة من اليوريك أسيد في الدم وارتفاعه.
المعدّل الطبيعي لليوريك أسيد عند النساء 2.4 – 6 مليجرام/ديسيلتر، أمّا عند الرجال 3.4 – 7 مليجرام/ديسيلتر، ويختلف هذا المعدَل من مختبر إلى آخر.
- الارتفاع الأولي لليوريك أسيد، وذلك بسبب:
- زيادة إنتاجه من مركب البيورين.
- عدم قدرة الكلية على إخراجه عن طريق البول، والتخلَص منه؛ ممّا يؤدي إلى ارتفاعه في الدم.
- الارتفاع الثانوي لليوريك أسيد، وذلك بسبب:
- بعض الأدوية التي تزيد من هذا الارتفاع مثل: مدرَات البول، والأدوية التي تستخدم لتعالج مرض الباركينسون.
- بعض الفيتامينات، كفيتامين B-3.
- أمراض في الكلية؛ مما يعيق وظيفتها في التخلّص من اليوريك أسيد الزائد.
- بعض عمليّات الأيض؛ كما في مرض الحُماض الأيضي “Metabolic acidosis” ، قد تؤدّي إلى ارتفاع اليوريك أسيد.
- ورم متلازمة انحلال” Tumor lysis syndrome”.
- قصور الغدة الدرقيًة” Hypothyroidism”.
- مرض الصدفية”Psoriasis “.
معظم الأشخاص لا تظهر عليهم أي أعراض، أمّا إذا ازداد هذا الارتفاع، قد يؤدّي إلى حدوث بعض الأمراض، منها:
- النقرس”Gout”؛ حيث إنّ زيادة نسبة اليوريك أسيد أكثر من 7 مليجرام/ديسيلتر؛ تؤدّي إلى تجمعه في المفاصل وحدوث هذا المرض عند 20% من الأشخاص، ومن أعراضه:
- وجع شديد في المفاصل.
- التهابات، وتورم في المفاصل.
- تقشَر الجلد حول المفصل المصاب.
- حصى الكلى kidney stones، بيّنت الدراسات أنّ 10% من الأشخاص المصابين بهذا المرض قد أصيبوا بارتفاع اليوريك أسيد، ومن أعراضه:
- ألم حاد ومفاجئ في البطن.
- بول مشوب بالدم.
- ألم عند التبول.
- الغثيان، والقيء.
- الفشل الكلوي kidney failure: وهو من أخطر الأمراض المرتبطة بارتفاع اليوريك أسيد، ومن أعراضه:
- صعوبة، وضيق التنفّس.
- انخفاض معدَل التبوّل.
- الشعور بالدوخة، أو التعب.
- ألم في الصدر.
- نذكر هنا الأطعمة التي تحتوي على كميات كبيرة البيورين؛ حيث يجب تجنّب تناول مثل هذه الأطعمة؛ لأنها تقوم بإنتاج اليوريك أسيد، و زيادة نسبته، ومنها:
- الخميرة، أو منتجاتها( كالبيرة، والكحول).
- السبانخ.
- الفاصولياء.
- البازلاء.
- العدس.
- الشوفان.
- القرنبيط.
- الفطر.
- الأطعمة التي تحتوي على كميات قليلة من البيورين؛ حيث يجب الإكثار من هذه الأطعمة، و منها:
- الحليب، أو منتجاته.
- الخضروات الخضراء مثل الخس، وأيضاً البندورة.
- الفاكهة.
- الفول السوداني، والبندق.
- تناول الأطعمة التي تحتوي على كميات قليلة من البيورين، للتقليل من خطورة الارتفاع.
- تجنب شرب الكحول، والكافيين.
- تجنّب أخذ الأدوية التي ترفع مستوى اليوريك أسيد في الدم، مثل مدرات البول (مدرات الثيازايد Thiazide diuretics، ومدرات اللوب Loop diuretics)، أو الأسبرين (Aspirin).
- إعطاء الأدوية التي تمنع امتصاص اليوريك أسيد، مثل: بروبينسيد Probenecid.
- إعطاء الأدوية التي تمنع إنتاج اليوريك أسيد، أو تساعد على إخراجه من الجسم، والتخلَص منه، مثل: ألوبيورينول Allupurinol، وسالفينبايرازون Sulfinpyrazone .
هذا المقال لا يعتمد كمرجع علمي، و لا يغنيك عن استشارة الطبيب.
- www.chemocare.com
- www.mayoclinic.org
- www.m.md-health.com
يجب أن يتخلص الجسم من هذا الحمض أولاً بأول، لكن إن ارتفعت نسبته في الجسم، ما الذي سيحدث؟ :